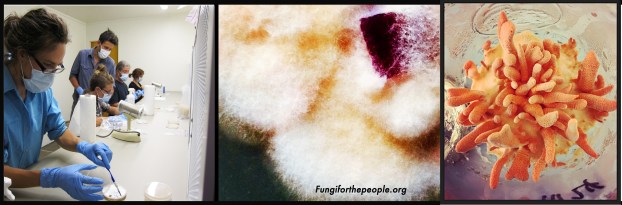

Cultivation workshop covering techniques and new findings on Cordyceps militaris mushrooms, led by William Padilla-Brown of MycoSymbiotics from North Carolina, with Ja Schindler of Fungi for the People.
William Padilla-Brown has been studying new techniques in Cordyceps culture and has begun producing C. militaris from non-pupal mediums at their lab in North Carolina. He is visiting to share and connect with other cultivators and scientists interested in Cordyceps culture. We welcome William as a guest presenter.
The workshop will be held at the research and production labs of Fungi for the People in Fall Creek, Oregon. Facilities provided for microscopy and tissue culture hands-on study. We will be practicing and detailing techniques on Cordyceps lifecycle, media preparations, culture techniques, environmental conditions to promote mushroom formation, and harvesting practices.
Saturday April 14th, 2018 11am – 5pm
________________________
Workshop Includes:
- Presentations on Cordyceps introduction and cultivation techniques
- Laboratory procedures detailed
- Hands-on Sessions in the Lab
- Live Cultures to take home
- Cordyceps growing workbook
- Seasonal Vegetarian Lunch by Valerie Nguyen
- Q & A with William and Ja
_______________________
Online Pre-Pay Registration : $70 Register Here
or Pay-at-event Registration : $90 Fill in Form Below
_______________________
10% Discount for Students and Mycological Society Members
Address of workshop given once registration is completed